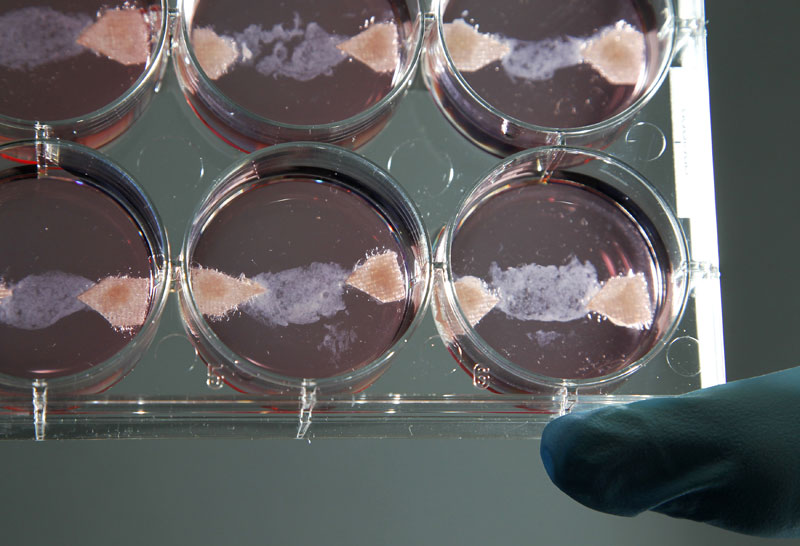

细胞肉专题(一) | 四大关键技术问题还需突破
收藏
关键词:
突破细胞
资讯来源:易企说17Talk + 订阅账号
发布时间:
2021-10-22
不过若干年后吃到的烧烤可能会有点特殊,吃到的并不是“真肉”,牛肉串、鸡肉丸和鱼排等都是细胞培养肉。细胞培养肉是人造肉的一种,与市场上常见的植物肉不同,细胞培养肉是指利用细胞培养工程和组织工程等技术,在体外培养动物肌肉组织作为食用材料。
现在,想要吃到这些细胞培养肉只能等到这些公司举办的试吃会,因为细胞培养肉目前还处于研发阶段,相关政策法规也尚待完善,世界上仅有新加坡允许细胞培养肉的售卖,其市场上也仅有一款 Eat Just 公司的细胞培养鸡肉产品。
而处于研发阶段的细胞培养肉产品则五花八门,品类囊括牛肉、猪肉、鸡肉、羊肉和海鲜等等,几乎覆盖了从平原到高地、从沿海到内陆的大部分人的饮食菜谱。
未来的主要人造肉手段
细胞培养肉的概念由英国前首相丘吉尔于 1932 年首次提出,他在发表的论文《从此以后的五十年》中写道:“我们不应该为了吃鸡胸肉或鸡翅而饲养一整只鸡,而应该在合适的培养基中分别培养这些组织。”
对于传统养殖业来说,粮食转化为肉类的效率较低,因为伴随着动物生长过程中的消耗以及转化为非肌肉组织的部分。而细胞培养肉可以高效的将营养转化为可食用的肉类细胞。
全国政协委员孙宝国曾指出,传统肉类生产方式是以消耗大量粮食和水资源、严重污染环境为代价的。随着经济发展、人口膨胀和中等收入人群的大幅增加,全球肉品需求正快速增加,传统肉类生产方式已越来越难以满足人类需求。人类亟须一种高效、环保、可持续的新型肉类生产方式,以满足未来人类的肉品供应。
在 2011 年的一项研究中,牛津大学和阿姆斯特丹大学的科学家估计,与传统养殖肉类相比,细胞培养肉类可能需要的能量减少 35% 到 60%,占用的土地减少 98%,产生的温室气体减少 80% 到 95%。
但细胞培养肉的研究进展缓慢,主要原因之一是实验室培养所需的巨大成本。2013 年荷兰科学家 Mark Post 组织了世界首个细胞培养牛肉汉堡公开试吃活动并公布了技术细节,汉堡中的牛肉饼是他在实验室中用牛干细胞培育的肉制成的,估计成本为
375,000 美元
。
10 多年过去,目前仍鲜有公司能够将细胞培养肉的成本降低至真实肉类的市场价以下。
南京农业大学周光宏曾公开指出:“
让细胞培养肉成本从每克 300 元降到 3 元甚至是三毛,才有可能走上餐桌,这一过程大约需要 5-10 年。
”
2019 年底周光宏团队培养出中国第一块肌肉干细胞培养肉,该团队使用第六代猪肌肉干细胞,经过前后 20 天的培养,得到重达 5 克的培养肉。
人体受伤的肌肉可以重新生长,是因为其中具有分化能力的干细胞,从理论上推导,
1 克肌肉中含有 1000 个干细胞,如果让其充分生长分裂,能产生 2 万千克的培养肉。
也就是说,几只动物或许就能完全供应全世界人口的肉食需求。
图丨未来食品的生物制造(来源:周景文,等:未来食品的发展:植物蛋白肉与细胞培养肉)
中国工程院院士、江南大学生物工程学院陈坚教授曾指出,细胞培养肉在营养、口感和风味方面可能更接近真实肉制品,在资源可持续和环境保护方面潜力巨大,是未来人造肉的主要研究发展方向,但是目前仍在理论与技术层面, 特别是肌肉脂肪组织大规模低成本培养等方面,还存在诸多挑战。
细胞培养肉关键技术
细胞培养肉研究的关键问题集中在初始细胞来源、细胞增殖分化能力、体外动物细胞组织的形成以及培养体系优化等方面。
在动物细胞组织培养过程中,需要面临的首要挑战是从组织中分离出大量具有均一性的初始细胞,确保后续能够进行有效增殖分化,从而实现人造肉的大规模生产。
目前动物组织工程细胞培养细胞来源主要是分离原生组织中的干细胞,例如胚胎干细胞、肌肉干细胞等。其中肌肉干细胞和间充质干细胞是人造肉研究中应用最为广泛的,它们在增殖过程中可以经过特殊化学、生物诱导或机械刺激分化形成不同细胞。
图丨潜在的可应用于细胞培养的干细胞来源(来源:周景文,等:未来食品的发展:植物蛋白肉与细胞培养肉)
干细胞与组织工程领域的发展为大规模人造肉的生产提供了可能性。细胞培养人造肉的生产需要通过大量分裂分化的肌肉细胞形成组织,但是大多数细胞在自然死亡前的分裂次数是有限的,也被称为海弗利克极限,这就限制了实验室肌肉细胞组织的大规模培养。
增加细胞的再生潜能是另一种增强动物细胞持续增殖能力的有效方式。
例如,海弗利克极限是通过端粒长度来确定的,其中的端粒是位于线状染色体的末端富含鸟嘌呤的重复序列。在线性染色体不断复制过程中,端粒会随着每一轮复制而缩短,进而影响细胞再生能力。
自然状态下的动物肌肉细胞为附着生长,并嵌入到相应组织中。为了模拟体内环境,体外肌肉细胞培养需要利用合适的支架体系进行粘附支撑生长,辅助形成细胞组织纹理及微观结构,维持肌肉组织三维结构。
现有的支架因其形状、组成和特性分成不同类型,其中最为理想的支架系统应该具有相对较大的比表面积用于细胞依附生长,可灵活地收缩扩张,模拟体内环境的细胞粘附等因素,并且易于与培养组织分离。
大规模体外培养细胞面临着被微生物污染或受自身代谢物质影响的难题,因此,在进行体外细胞培养时,要及时清除细胞产生的代谢废物,为体外培养细胞提供无菌无毒的生存环境。传统的细胞培养阶段都使用动物血清提供细胞贴壁、增殖和分化所需的营养成分和生物因子,并且往往需要添加抗生素或抗有丝分裂剂,不能满足食品安全要求。
无血清培养体系包括无血清培养基的开发、适应细胞株的驯化以及细胞规模化培养等关键技术。
近年的研究证明,无血清培养基对细胞的生长速率、细胞密度、产物及蛋白表达水平都不亚于血清培养基,并且可以通过精确控制无血清培养基组分调控细胞的增殖分化节点,其显著的优势将使无血清培养技术逐步取代含血清细胞培养。
国家政策推动
目前,世界各国在针对合成生物食品商业化问题上并未建立专门且具体的法律规范和管理措施,但普遍采用现有的法律框架进行生物安全评价和监管。
在国际层面,合成生物食品研究、制备过程中对生物多样性的影响受 1993 年生效的《生物多样性公约》(Convention on Biological Diversity)约束。缔约国在开展合成生物食品研究和应用时,应遵循公约的要求,承担保护自然生物资源和可持续发展的条约义务。欧美国家目前选择适用现有的评估普通食品、转基因、微生物和生物技术等法律框架对合成生物食品商业化可能引发的生物安全、食品安全及伦理争议等风险进行监管。
我国政策对于合成生物食品的研发整体上持支持态度。我国 “863 计划” 和 “973 计划” 都将生物技术(合成生物学 - 食品)纳入重点资助领域。
2010—2019 年间,我国国家自然科学基金针对合成生物食品的研究资助项目共计 23 个。
根据中国科学技术部《国家重点研发计划 “合成生物学” 等重点专项 2019 年度项目申报指南》的数据,2019 年我国拟投入国拨经费 6 亿元以支持合成生物学技术在食品、医药和能源等领域的研究创新。同时,我国亦鼓励建立合成生物产业创新中心,辅以国家投资、政策支持培育孵化具有核心竞争力的合成生物科技企业。
中国 “十四五” 明确指出加强生物安全风险防控。建立健全生物安全风险防控和治理体系,全面提高国家生物安全治理能力。统筹布局生物安全基础设施,构建国家生物数据中心体系,加强高级别生物安全实验室体系建设和运行管理。强化生物安全资源监管,制定完善人类遗传资源和生物资源目录,建立健全生物技术研究开发风险评估机制,推进生物安全法实施。
全国政协委员孙宝国曾指出,
我国细胞培养肉研发尚处于起步阶段,产业化发展仍然有很长的路要走。
与欧美国家相比,我国对食品营养风味的需求更具多样性,不仅要开发与欧美国家相似的技术,还需要大量的自主创新。因此,进行细胞培养肉相关的研究对打破发达国家在该领域的技术垄断、保障我国未来肉品供应、占领人造肉生产技术制高点,具有重要的战略意义。
Guoqiang Zhang, Xinrui Zhao, Xueliang Li, et al., Application of cell culture techniques in cultured meat-a review, Chinese journal of biotechnology, 2019
周景文,等:未来食品的发展:植物蛋白肉与细胞培养肉
https://www.science.org/content/article/here-it-comes-375000-lab-grown-beef-burger
易企融资系列课—史上最强生物药企融资全流程实用手册,避“坑”指南!
易贸医疗在线携手易企说邀请到易凯资本、普华永道、约印医疗基金、天超资本等合伙人为初创融资企业家共同打造“易企融资系列课—史上最强生物药企融资全流程实用手册,避“坑”指南!”
更有机会能获得免费的线上路演机会,直面投资机构进行洽谈。
扫描海报二维码,即可免费报名,名额有限,仅开放于有融资需求的高层管理人员!

个人中心
个人中心
 我是园区
我是园区






